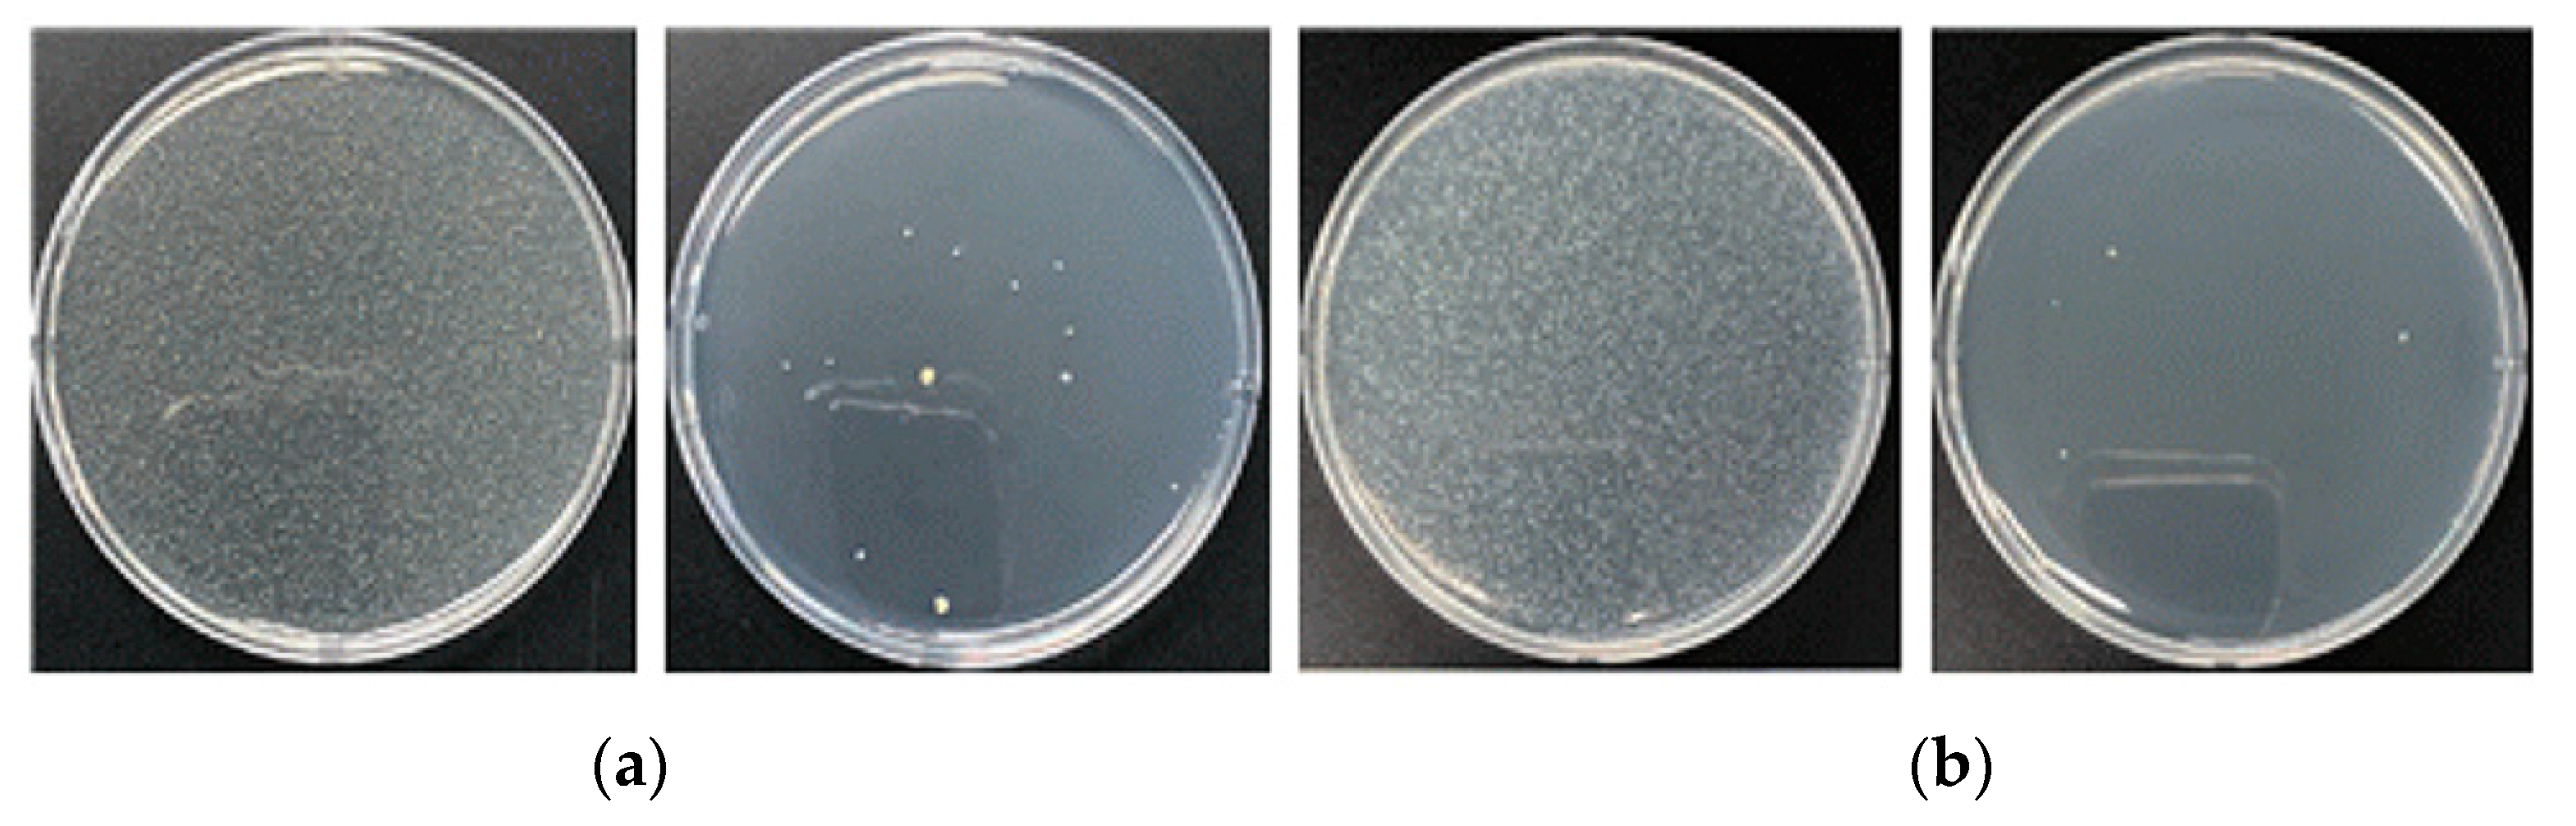
Nanomaterials 13 02071 g009 Nanomaterials 13 02071 g009

Development of Nano-Sized Copper-Deposited Antimicrobial Air Filters Using a Mixed Melt-Blown Process
Abstract
1. Introduction
2. Materials and Methods
2.1. Method for Applying Antimicrobials and Test Antimicrobial Particle Dispersion
2.2. Performance Evaluation Test of Antimicrobial Filter
2.2.1. Antimicrobial Performance via Antimicrobial Treatment Concentration
2.2.2. Antimicrobial and Antifungal Testing of the Antimicrobial Filter
2.2.3. Airborne Bacteria Removal Performance of the Antimicrobial Filter
2.3. Basic Performance of the Filter and Antimicrobial Safety Test
3. Results
3.1. Antimicrobial Dispersion Test Results
3.2. Antimicrobial Performance
3.2.1. Antimicrobial Effectiveness Based on the Concentration of Antimicrobial Agents
3.2.2. Optimized Concentration Filtration Antibacterial and Antifungal Test Results
3.2.3. Suspended Bacteria Test Results
3.3. Basic Performance of the Filter and Safety Test Results
3.3.1. Basic Performance (Differential Pressure and Efficiency)
3.3.2. Safety Test Results
4. Conclusions
Author Contributions
Funding
Data Availability Statement
Conflicts of Interest
References
- Yang, W.; Lee, K.; Yoon, C.; Yu, S.; Park, K.; Choi, W. Determinants of residential indoor and transportation activity times in Korea. J. Expo. Sci. Environ. Epidemiol. 2011, 21, 310–316. [Google Scholar] [CrossRef]
- Möritz, M.; Peters, H.; Nipko, B.; Rüden, H. Capability of air filters to retain airborne bacteria and molds in heating, ventilating and air-conditioning (HVAC) systems. Int. J. Hyg. Environ. Health 2001, 203, 401–409. [Google Scholar] [CrossRef] [PubMed]
- Flemming, H.C. Biofilms and environmental protection. Water Sci. Technol. 1993, 27, 1–10. [Google Scholar] [CrossRef]
- Grass, G.; Rensing, C.; Solioz, M. Metallic copper as an antimicrobial surface. Appl. Environ. Microbiol. 2011, 77, 1541–1547. [Google Scholar] [CrossRef] [PubMed]
- Gross, T.M.; Lahiri, J.; Golas, A.; Luo, J.; Verrier, F.; Kurzejewski, J.L.; Baker, D.E.; Wang, J.; Novak, P.F.; Snyder, M.J. Copper-containing glass ceramic with high antimicrobial efficacy. Nat. Commun. 2019, 10, 1979. [Google Scholar] [CrossRef] [PubMed]
- Van Doremalen, N.; Bushmaker, T.; Morris, D.H.; Holbrook, M.G.; Gamble, A.; Williamson, B.N.; Tamin, A.; Harcourt, J.L.; Thornburg, N.J.; Gerber, S.I.; et al. Aerosol and surface stability of SARS-CoV-2 as compared with SARS-CoV-1. N. Engl. J. Med. 2020, 382, 1564–1567. [Google Scholar] [CrossRef] [PubMed]
- Ishida, T. Antiviral activities of Cu2+ ions in viral prevention, replication, RNA degradation, and for antiviral efficacies of lytic virus, Ros-Mediated Virus, Copper Chelation. World Sci. News 2018, 99, 148–168. [Google Scholar]
- Yoon, Y.H.; Nam, S.H.; Joo, J.C.; Ahn, H.S. Photocatalytic disinfection of indoor suspended microorganisms (Escherichia coli and Bacillus subtilis spore) with ultraviolet light. J. Korea Acad-Ind. Coop. Soc. 2014, 15, 1204–1210. [Google Scholar] [CrossRef]
- Gaunt, L.F.; Higgins, S.C.; Hughes, J.F. Interaction of air ions and bactericidal vapours to control micro-organisms. J. Appl. Microbiol. 2005, 99, 1324–1329. [Google Scholar] [CrossRef] [PubMed]
- Lee, H.G.; Kim, T.H.; Jung, J.S.; Kim, J.G. A Basic Study on Inner Air Filter Sterilization System Using Ozone; The Korean Institute of Electrical Engineers: Seoul, Republic of Korea, 2015; pp. 1206–1207. [Google Scholar]
- Lytle, K.L.; Collins, S.P.; Wesley, H. Self Influenza vaccine acceptance and hesitancy among adults hospitalized with severe acute respiratory illnesses, United States 2019–2020. Vaccine 2021, 39, 5271–5276. [Google Scholar] [CrossRef] [PubMed]
- Malachová, K.; Praus, P.; Rybková, Z.; Kozák, O. Antibacterial and antifungal activities of silver, copper and zinc montmorillonites. Appl. Clay Sci. 2011, 53, 642–645. [Google Scholar] [CrossRef]
- Woo, C.G.; Kang, J.S.; Kim, H.J.; Kim, Y.J.; Han, B. Treatment of air filters using the antimicrobial natural products propolis and grapefruit seed extract for deactivation of bioaerosols. Aerosol Sci. Technol. 2015, 49, 611–619. [Google Scholar] [CrossRef]

| Blank | Original | Cu 3% | Cu 6% | Cu 10% | |
|---|---|---|---|---|---|
| Concentration (cfu/mL) | 6.6 × 105 | 6.7 × 105 | 8.8 × 103 | 1.2 × 102 | 45 |
| Inhibition rate (%) | - | 0 | 98.7 | 99.9 | 99.9 |
| Test Item | Test Result | |
|---|---|---|
| Control | Sample | |
| Staphylococcus | 6.6 × 105 | 2.8 × 102 99.9% |
| Klebsiella pneumoniae | 3.0 × 106 | <10 99.9% |
| Test Item | Test Result | Test Condition | ||
|---|---|---|---|---|
| Before Operation (CFU/m3) | After Operation (CFU/m3) | Removal Rate (%) | ||
| S. Aureus | 1.2 × 104 | <10 | 99.9 | 23.0 °C ± 0.2 °C 50.5% ± 3.0% R.H. |
| Test Item | Test Result | Test Method | |
|---|---|---|---|
| Efficiency (%) | Resistance (Pa) | ||
| H13 (Original) | 99.98 | 33.7 | EN 1822-3 (Flat sheet media) |
| H13 (Cu 3%) | 99.98 | 34.2 | |
| H13 (Cu 6%) | 99.97 | 32.2 | |
| H13 (Cu 10%) | 99.97 | 30.6 | |
Disclaimer/Publisher’s Note: The statements, opinions and data contained in all publications are solely those of the individual author(s) and contributor(s) and not of MDPI and/or the editor(s). MDPI and/or the editor(s) disclaim responsibility for any injury to people or property resulting from any ideas, methods, instructions or products referred to in the content. |
© 2023 by the authors. Licensee MDPI, Basel, Switzerland. This article is an open access article distributed under the terms and conditions of the Creative Commons Attribution (CC BY) license (https://creativecommons.org/licenses/by/4.0/).
Share and Cite
Lee, K.H.; Yoo, J.Y.; Park, C.J.; Ahn, K.H. Development of Nano-Sized Copper-Deposited Antimicrobial Air Filters Using a Mixed Melt-Blown Process. Nanomaterials 2023, 13, 2071. https://doi.org/10.3390/nano13142071
Lee KH, Yoo JY, Park CJ, Ahn KH. Development of Nano-Sized Copper-Deposited Antimicrobial Air Filters Using a Mixed Melt-Blown Process. Nanomaterials. 2023; 13(14):2071. https://doi.org/10.3390/nano13142071
Chicago/Turabian StyleLee, Kyung Hwan, Jun Young Yoo, Chan Jung Park, and Kang Ho Ahn. 2023. "Development of Nano-Sized Copper-Deposited Antimicrobial Air Filters Using a Mixed Melt-Blown Process" Nanomaterials 13, no. 14: 2071. https://doi.org/10.3390/nano13142071
APA StyleLee, K. H., Yoo, J. Y., Park, C. J., & Ahn, K. H. (2023). Development of Nano-Sized Copper-Deposited Antimicrobial Air Filters Using a Mixed Melt-Blown Process. Nanomaterials, 13(14), 2071. https://doi.org/10.3390/nano13142071

